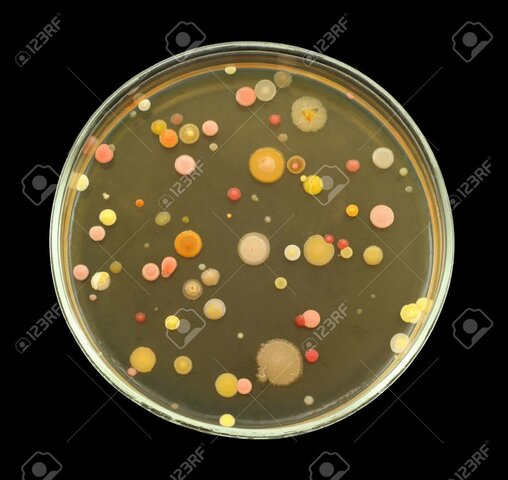
Koch y la tuberculosis

-
 El microscopio fue inventado por Zacharias Janssen
El microscopio fue inventado por Zacharias Janssen -
-
 El primero que observó las bacterias, las células microbianas
El primero que observó las bacterias, las células microbianas
más pequeñas, fue Antoni van Leeuwenhoek (1632-1723), un
holandés vendedor de telas y aficionado a la microscopía.Las descubrió en mientras estudiaba
infusiones de pimienta, e informó de sus investigaciones
en una serie de cartas a la prestigiosa Royal Society de Londres -
-
 Louis Pasteur puso fin a la Generación Espontánea gracias al Matraz de Pasteur, este mediante el uso de calor, descubrió que si se calentaba considerablemente una solución nutritiva y después se precintaba no se pudría, ya que, sostenía que la putrefacción del material nutritivo provenían de microrganismos ya presentes en el material o de microorganismos transportados por el aire.
Louis Pasteur puso fin a la Generación Espontánea gracias al Matraz de Pasteur, este mediante el uso de calor, descubrió que si se calentaba considerablemente una solución nutritiva y después se precintaba no se pudría, ya que, sostenía que la putrefacción del material nutritivo provenían de microrganismos ya presentes en el material o de microorganismos transportados por el aire. -
 Koch investigo sobre las causas y efectos con respecto a la relación de la bacteria y la enfermedad. Formulo postulados, denominados Postulados de Koch y con estos postulados como guía, Koch, sus estudiantes y los que les siguieron descubrieron los agentes causantes de la mayoría de las enfermedades infecciosas. También, llevaron al desarrollo de tratamientos adecuados para la prevención y la cura de muchas de estas enfermedades.
Koch investigo sobre las causas y efectos con respecto a la relación de la bacteria y la enfermedad. Formulo postulados, denominados Postulados de Koch y con estos postulados como guía, Koch, sus estudiantes y los que les siguieron descubrieron los agentes causantes de la mayoría de las enfermedades infecciosas. También, llevaron al desarrollo de tratamientos adecuados para la prevención y la cura de muchas de estas enfermedades. -
Koch descubrio la bacteria causante de la tuberculosis (Mycobacterium tuberculosis) gracias al empleo de sus postulados, y tambien descubrio que estas bacterias se organizaban en "colonias".
Koch descubrio la bacteria causante de la tuberculosis (Mycobacterium tuberculosis) gracias al empleo de sus postulados, y tambien descubrio que estas bacterias se organizaban en "colonias".
en 1905 recibio el premio nobel por este descubrimiento -
-
 Winogradsky descubrio que las bacterias que usan compuestos de nitrogeno y azufre catalizaban transformaciones químicas específicas en la naturaleza, y propuso el importante concepto de
Winogradsky descubrio que las bacterias que usan compuestos de nitrogeno y azufre catalizaban transformaciones químicas específicas en la naturaleza, y propuso el importante concepto de
"quimiolitotrofia" (significa"Comedores de tierra"), la oxidación de compuestos inorgánicos para obtener energía. Tambien fue el primero en aislar una bacteria fijadora de nitrogeno. -
 La mayor contribución de Beijerinck al campo de la microbiología fue la técnica del cultivo de enriquecimiento. En el cual, los microorganismos se aíslan de muestras naturales mediante nutrientes y condiciones de incubación muy selectivos para favorecer un grupo metabólico concreto de organismos. Beijerinck aisló los primeros cultivos puros de muchos microorganismos edáficos y acuáticos, como las bacterias reductoras de sulfato y mucho más.
La mayor contribución de Beijerinck al campo de la microbiología fue la técnica del cultivo de enriquecimiento. En el cual, los microorganismos se aíslan de muestras naturales mediante nutrientes y condiciones de incubación muy selectivos para favorecer un grupo metabólico concreto de organismos. Beijerinck aisló los primeros cultivos puros de muchos microorganismos edáficos y acuáticos, como las bacterias reductoras de sulfato y mucho más.
Plan projects on a visual timeline
Map milestones, phases, deadlines, and key events in one place so the sequence is easier to see and share. Timetoast is a timeline maker for work, school, research, and stories.